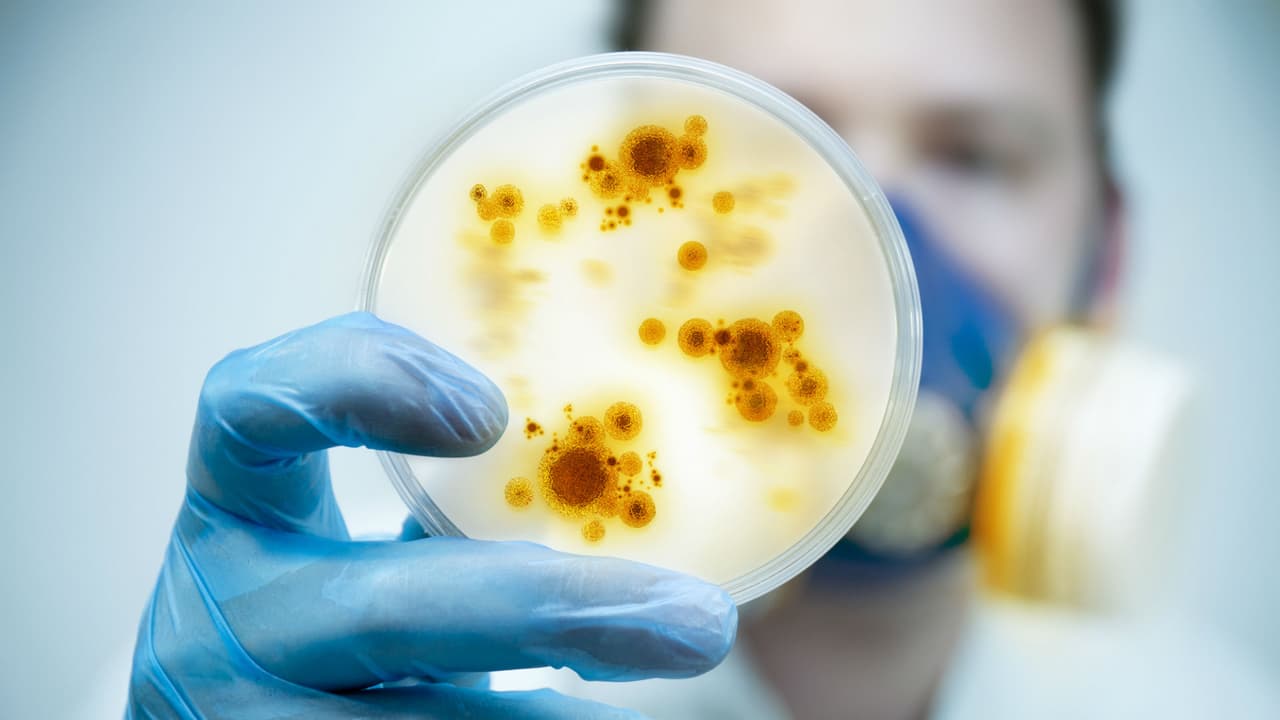

Científicos erradicarían enfermedades hereditarias en el futuro
La transcripción se genera mediante el uso de inteligencia artificial y puede contener errores o inexactitudes. En caso de una discrepancia, prevalece el audio.
Encuentra pófugo. El táfico de personas genera entre 600 y 800.
000 $ anuales a quienes lucran de este crimen. Un futuro sin enfermedades hereditarias dejaía de pertenecer al mundo de la ciencia ficcón.
Investigadores logra modificar los genes de embriones humanos, un paso decisivo para eliminar los padecimientos entre diferentes generaciones. Miembros de la